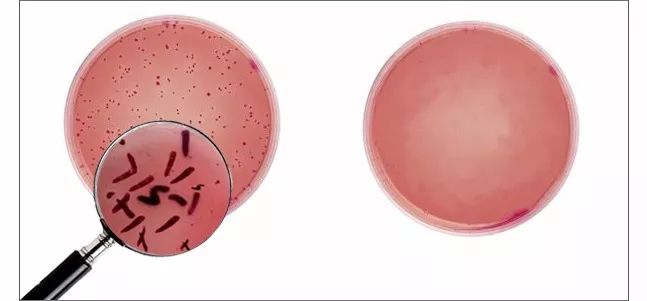

还以为冰箱是美食保险箱吗
水果蔬菜/剩饭/鸡蛋/牛奶/全往里塞
开冰箱时总闻到臭臭的异味
冰箱没坏!食材也没买几天呢
为什么这么臭?
这不只是食物混放发酵的串味儿
是长期藏在冰箱里
各种细菌群代谢的有害气体!

这几年“冰箱病”频繁上热搜
证实了冰箱其实是个细菌窝
连保鲜膜、保鲜袋也被曝光
不仅费钱费力、还会招新细菌

想去除冰箱臭味、细菌,远离冰箱病
就往冰箱里放这个小东西
↓↓↓
黑科技活氧净化器
专治冰箱等狭小空间的除味、杀菌
1
根除异味、臭味:让冰箱时刻干净卫生、
气味清新。
2
杀灭99.9%细菌:用臭氧杀菌、降解
果蔬农药残留,不产生任何有害物质。
3
让食物保鲜时间延长3倍:让食材
省一半钱,冰箱多活5年。

它 为 什 么 能 除 味?
原来是利用臭氧的超强氧化性
它能释放臭氧,让臭氧将异味分子分解掉!
除味效果是活性炭的10倍!


小编用烟气模拟异味气体
打开活氧净化器释放臭氧
短短几秒钟烟气就消失了
烟的味道完全也闻不到了
干净清新的空气扑鼻而来

快把冰箱里的柚子皮、活性炭扔掉吧
柚子皮只是气味大盖住了冰箱的臭味
活性炭也只是把臭味分子吸附而已
臭味没了细菌却翻倍涨
只是你肉眼看不见...

有了它以后,打开冰箱就想深呼吸
清洁冰箱、给冰箱除味的累活儿
再也不用动手洗刷刷~

▼
把食物放冰箱冷藏2小时后
细菌就开始疯狂裂变,不到一天细菌数就上亿了
可冰箱本身只会保鲜,不会杀菌啊!
如果不给冰箱杀菌
食物就带着细菌一起下肚了

把它放冰箱里能杀掉99.9%的细菌
因为臭氧就是细菌的天敌
能将细菌分解并转化成水、二氧化碳和氧气
没有任何有害物和残留产生
是最安全最健康的杀菌方法

平时把鲜肉放冰箱冷藏两天就臭了
把它放冰箱杀菌冷藏
肉都放一周了还很新鲜!
以后往冰箱放肉菜、剩饭不用套保鲜膜啦

↓ 细菌数量对比 ↓
它还能让冰箱食物保鲜期延长3倍
买食材的钱能省一大半
冰箱的寿命也能多三五年
小编用苹果试了一下
把苹果分别放进无、有Enerfer的冰箱里

15天后取出,明显可以看到
普通冰箱保鲜的苹果已经发蔫儿了
有活氧净化器保鲜的苹果还鲜嫩如初~

黑科技活氧净化器的出现
用实力淘汰了所有除味杀菌方法
有冰箱就必须有它!

臭氧是臭的吗?NO!
记得大雷雨过后清新自然的空气味道么
这股淡淡的鲜草味就是臭氧!
在森林、瀑布、海边的臭氧味更明显
臭氧在大气中阻挡/分解各类有害物质
被称为地球最好的保姆 ~

卫生间的臭味和细菌它也能完全去除
让洗手间像大海边一样空气清新
上个厕所就感觉 好 嗨 呦~

各种新闻都报道过
车内甲醛、二手烟、肉眼不见的细菌超标
把TA在车上放一宿
第二天就能呼吸最清新健康的空气啦
开车上班就像出去旅行一样

让活氧净化器在鞋柜里也待两天
遭人嫌弃的臭脚臭鞋味竟然都没啦
凑着鞋子使劲闻都没闻到~

黑科技净化器释放的臭氧浓度为0.1PPM
还有三档模式可以选择
是最科学、健康的臭氧释放模式
有国家专业权威的质检报告

活氧净化器被无数生活达人安利
各种好评、晒图满天飞
内涵和颜值都逼格满满呀
藏不住的高级感,真给家里添彩~

不用插电、不用清洗、0耗材
充1次电能用2个月
只需打开开关,往需要的地方一放
给全家请了一个健康保姆

满满黑科技于一身的冰箱活氧净化器
别看它那么小,能用三年呢!
春季粉丝特惠价只需99元
相当于每天不到1毛钱
你不试试吗?!

写下你的想法